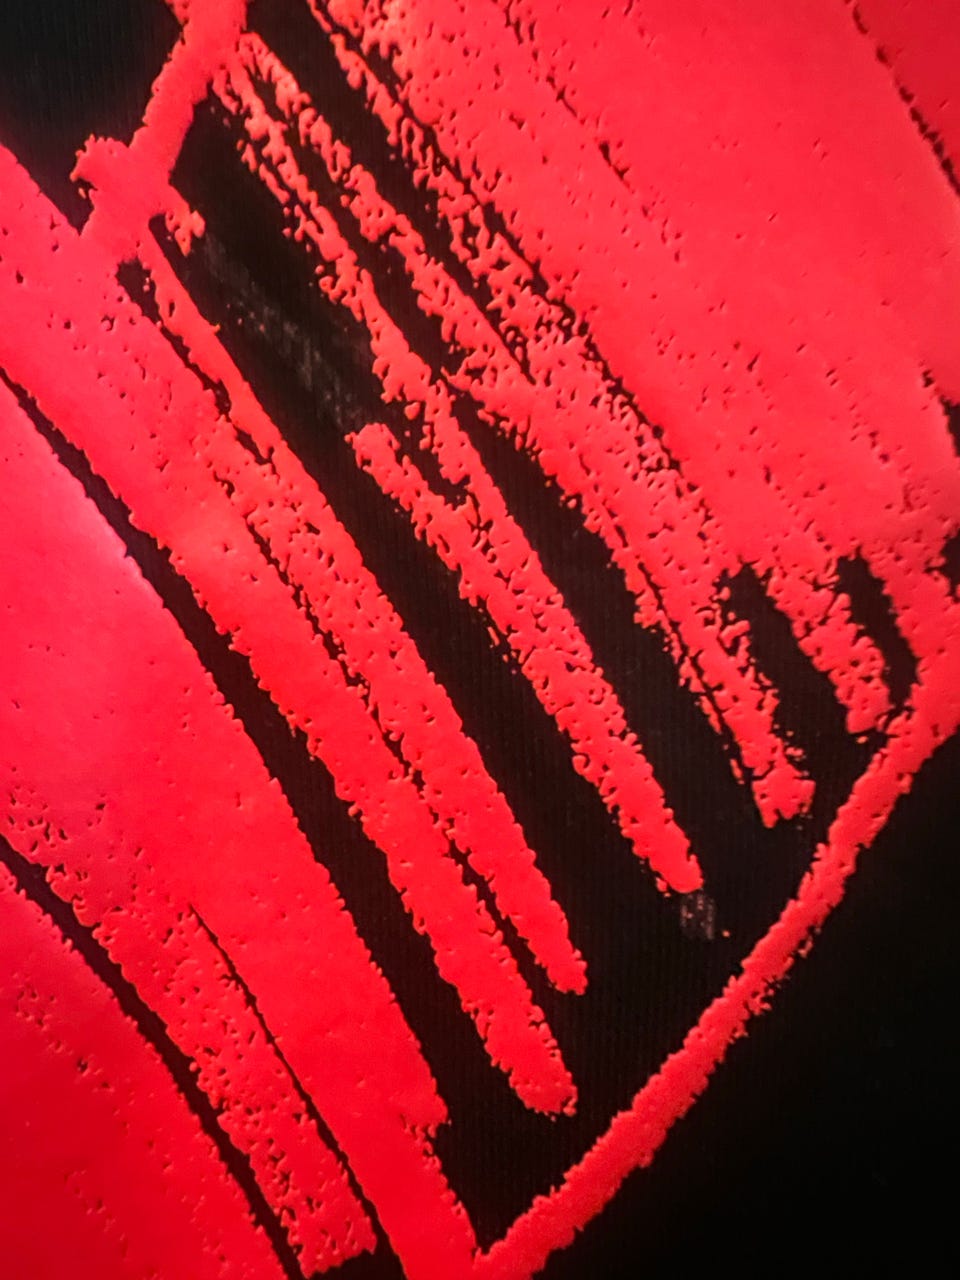
Galleribilde

Bildegalleri
(1/5)
Moschino genser str. XS/34
Til salgs
Fiks ferdig
500 kr
Frakt fra 39 kr + Trygg betaling 51 kr
Trygg handel med Fiks ferdig
Varen sendes til deg, og du har 24 timer til å inspisere den før pengene overføres til selgeren.
Beskrivelse av varen
Tilstand: Pent brukt - I god stand
Størrelse: XS
Type: Genser
Farge: Svart
Pent brukt genser fra Moschino som ble kjøpt på Zalando i 2024. Original pris lå på 3695. Selger denne billig da den har fått litt slitasje på hjertet. Ellers er den i veldig fin stand. Denne er i størrelse 34, som tilsvarer størrelse XS, men vil påstå at denne fint passer en Small også da den kan oppleves litt stor i størrelsen 😊
NB: Knappen for å vise hele beskrivelsen har kun en visuell effekt.
Brukerprofil

Du må være logget inn for å se brukerprofiler og sende meldinger.
Logg innAnnonsens metadata
Sist endret: 18.10.2025 kl. 20:00 ・ FINN-kode: 422707306
Utforsk våre nye sider for klær og mote
Ta en titt